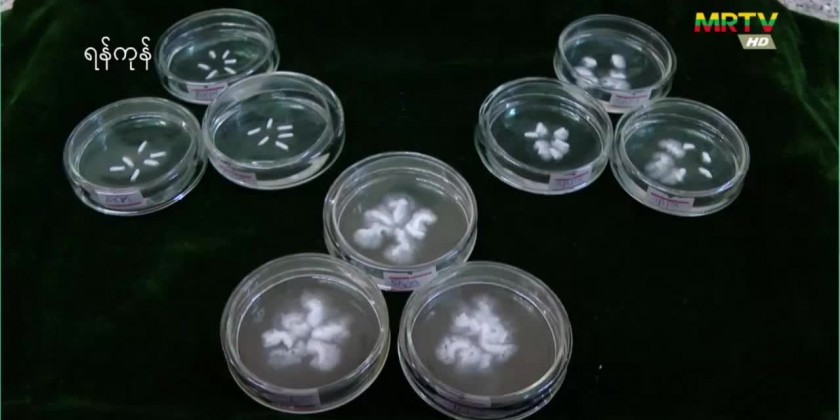

Under the Ministry of Agriculture, Livestock and Irrigation, the Plant Biotechnology Center (PBC) conducts grain quality electronic and crop quality&nutrient testing processes that are important for the cultivation of plant issues.
According to the Officer of the Center, The small and large amount of nutrients, hormones, vitamins, minerals and sugar are needed to grow the plant issues.
Aye Sandar Aung, Dy Staff Officer, PBC said “The grain quality and nutrient testing processesare aimed to produce high quality of rice varieties in climatechange.We measure the pieces,length and width of grain for physical property as the rice quality check. Also the physiognomy property is used to measure starch containment, temperature required during cooking and long term production of starch. We also test the difference between rice smell and taste.”
Currently, Chemical and Spectrophotometer are using for starch measurement. Also NIR machine can be used in future and it will be applied for measuring the strength, qualities, and beneficial compounds of rice and crops.
MITV is a broadcast TV brand intended for international and local English speaking consumers, launched on 31st March 2010 based in Yangon.